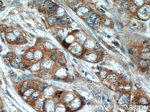
NBR1 Antibody in Immunohistochemistry (Paraffin) (IHC (P))

Search
Proteintech
NBR1 Polyclonal Antibody
{{$productOrderCtrl.translations['antibody.pdp.commerceCard.promotion.promotions']}}
{{$productOrderCtrl.translations['antibody.pdp.commerceCard.promotion.viewpromo']}}
{{$productOrderCtrl.translations['antibody.pdp.commerceCard.promotion.promocode']}}: {{promo.promoCode}} {{promo.promoTitle}} {{promo.promoDescription}}. {{$productOrderCtrl.translations['antibody.pdp.commerceCard.promotion.learnmore']}}
产品信息
16004-1-AP
种属反应
已发表种属
宿主/亚型
分类
类型
抗原
偶联物
形式
浓度
规格
纯化类型
保存液
内含物
保存条件
运输条件
产品详细信息
Immunogen sequence: MEPQVTLNV TFKNEIQSFL VSDPENTTWA DIEAMVKVSF DLNTIQIKYL DEENEEVSIN SQGEYEEALK MAVKQGNQLQ MQVHEGHHVV DEAPPPVVGA KRLAARAGKK PLAHYSSLVR VLGSDMKTPE DPAVQSFPLV PCDTDQPQDK PPDWFTSYLE TFREQVVNET VEKLEQKLHE KLVLQNPSLG SCPSEVSMPT SEETLFLPEN QFSWHIACNN CQRRIVGVRY QCSLCPSYNI CEDCEAGPYG HDTNHVLLKL RRPVVGSSEP FCHSKYSTPR LPAALEQVRL QKQVDKNFLK AEKQRLRAEK KQRKAEVKEL KKQLKLHRKI HLWNSIHGLQ SPKSPLGRPE SLLQ (1-353 aa encoded by BC009808)
靶标信息
The protein encoded by this gene was originally identified as an ovarian tumor antigen monitored in ovarian cancer. The encoded protein contains a B-box/coiled coil motif, which is present in many genes with transformation potential, but the function of this protein is unknown. This gene is located on a region of chromosome 17q21.1 that is in close proximity to tumor suppressor gene BRCA1. Three alternatively spliced variants encoding the same protein have been identified for this gene.
仅用于科研。不用于诊断过程。未经明确授权不得转售。
生物信息学
蛋白别名: B-box protein; Cell migration-inducing gene 19 protein; IAI3B; KIAA0049; Membrane component chromosome 17 surface marker 2; Membrane component chromosome 17 surface marker 2 homolog; membrane component, chromosome 17, surface marker 2 (ovarian carcinoma antigen CA125); MIG19; migration-inducing protein 19; neighbor of BRCA1 gene 1; Neighbor of BRCA1 gene 1 protein; Next to BRCA1 gene 1 protein; next to the Brca1; ovarian carcinoma antigen CA125; Protein 1A1-3B; unnamed protein product
基因别名: 1A1-3B; 1A13B; Ca125; IAI3B; KIAA0049; M17S2; MIG19; mKIAA0049; NBR1; RGD1311421
UniProt ID: (Human) Q14596, (Mouse) P97432, (Rat) Q501R9
Entrez Gene ID: (Human) 4077, (Mouse) 17966, (Rat) 303554